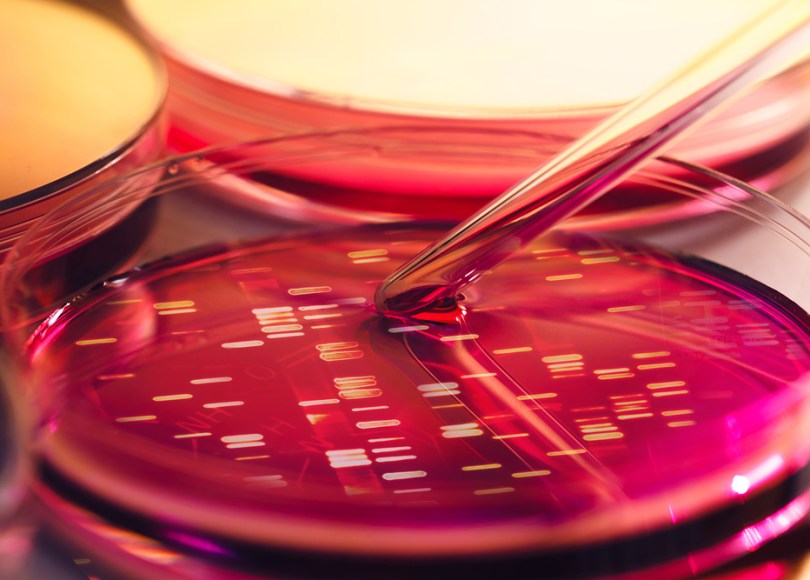
Researchers are using genomic studies to develop better treatments for metastatic breast cancer.

In a recent post, we looked at highlights of a major report on the status of metastatic breast cancer care and research. That report notes that progress against MBC has slowed and, over the past decade, only about 7% of research publications about breast cancer have been specifically about metastatic breast cancer. It also talked about several things that need to be done to accelerate progress and offered some hope that we are beginning to move in the right direction.
Shortly after writing that post, I attended an event where I learned about some fascinating MBC research that is going on now. The event was the 2016 Advocate Leadership Summit organized by the National Breast Cancer Coalition.
I’ll share here a few of my impressions from parts of the program that focused specifically on MBC research.
A large portion of NBCC’s Summit each year is devoted to updates on breast cancer research. This year there were presentations by prominent breast cancer researchers on a wide range of topics including vaccine development, health disparities, personalized medicine and the immune system, as well as on MBC research.
All of the scientists who spoke are working on innovative research approaches, recognizing that more of the same of what’s been done for years isn’t going to lead to real progress. But new ideas aren’t always easy to move forward and we also heard about some of the challenges they face.
One of the most thought-provoking panels I attended was on “Complexities of MBC Research”, and featured talks by two phenomenal researchers–Dr. Patricia Steeg and Dr. Corrie Painter.
Keeping Metastasis in Check
Dr. Patricia Steeg, a researcher with the National Cancer Institute, specializes in the study of breast cancer metastasis. She has a special focus on brain metastasis.
Dr. Steeg’s lab has discovered a gene that suppresses metastasis. Her team has also identified a potential therapy that could be used to boost the activity of this beneficial gene.
The potential treatment that Dr. Steeg is working on could benefit both patients without metastases or “mets” and patients who already have some mets to prevent the development of more and thus keep the disease in check.
Dr. Steeg and her team have been working hard for several years to try to get this potential therapy into clinical trials. But they face resistance from drug companies. She explained that the main reason for this is that the treatment does not shrink existing tumors, even though it prevents the development of new metastatic tumors. Drug companies are wary of this approach and reluctant to fund trials because it doesn’t fit the standard model of what a cancer drug is expected to do.
Developing Personalized Treatments
Developing personalized treatments for MBC has been hampered so far by a lack of necessary data from patients. Dr. Corrie Painter, a researcher and scientific outreach officer at the Broad Institute, spoke about the Metastatic Breast Cancer Project, which is working on that problem.
The Project is creating a national database of patients’ blood and tumor samples for use in genomic studies. Dr. Painter explained that the Project will be studying such questions as: what are the genes and mutations that can lead to MBC? what explains why some patients experience extraordinary responses to treatments while some tumors do not respond? and, how can we develop better treatments for MBC?
Dr. Painter explained that many of the problems in MBC research can be overcome by partnering with patients. And it’s not just a matter of donating tissue samples. “We want patients to understand that they’re going to help us design the studies,” she said. The Project is using social media as one of many avenues to engage directly with patients and involve them in research.
The Project will soon begin work on a blood biopsies study to find out whether we can obtain the same key genetic information about a tumor from a blood sample that we can get now only with a biopsy.
Targeting Metastatic Tumor Cells
Another innovative research approach was presented by Dr. Cyrus Ghajar, a researcher at the Fred Hutchinson Cancer Research Center. Dr. Ghajar spoke as a member of panel discussing what we know about preventing metastasis and ways to approach both preventing metastasis and slowing or stopping metastatic disease.
Dr. Ghajar’s lab has found that metastatic breast cancer cells that are dormant, i.e. not growing, tend to cluster around blood vessels in the organ they have migrated to. They’ve also found that there are substances active around those blood vessels that tend to make the cancer cells resistant to chemotherapy.
He and his team are working on a potential therapy that would target the factors that make metastatic tumor cells resistant to chemotherapy. This would allow for more effective use of chemotherapy, against both dormant cells and potentially against active metastatic cells as well.
Funding High Impact Breast Cancer Research
How do researchers like these who are willing to try novel approaches obtain funding for their work–research that may sometimes be considered too “high risk” to meet the requirements of traditional funders?
One way they may obtain funding is through the Department of Defense Breast Cancer Research Program. Dr. Steeg’s innovative metastasis research is an example of research that has come out of that program.
The DoD Breast Cancer Research Program was started in 1993 through the efforts of NBCC advocates, who continue to advocate for new funding each year. The program emphasizes innovation, high-impact research and transparency, with a vision of ending breast cancer.
One of the program’s major contributions has been research that led to development of the drug trastuzumab (Herceptin), an effective treatment for many patients with HER2-positive breast cancer. A more recent success has been research led by Dr. Dennis Slamon that resulted in development of the drug palbociclib (Ibrance), an FDA-approved targeted therapy for metastatic hormone-receptor positive breast cancer.
Much more information on the DoD Breast Cancer Research Program, its goals, and specific research projects can be found in the Program Booklet on its website.
Related Posts
Metastatic Breast Cancer: How Can We Accelerate Progress?
Clinical Trials: How Can Patients Benefit More?
Metastatic Breast Cancer: A Look at the Critical Need for Focused Research
Photo Credit: isak55 via Shutterstock
Thanks for the update!
BTW, It is older now, but the book HER2, and the movie Living Proof, about the making of Herceptin- really show the tangled path to clinical trials well.
Xo
I hadn’t thought of that, and I absolutely agree about the book HER2 by Bazell. It certainly does portray a tangled path for a drug that was very different and almost didn’t make it many times.